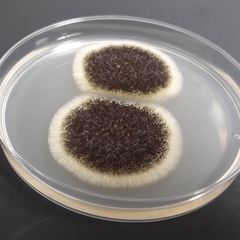
Aspergillus nigri (lr). Pesäkkeet erottuvat muista mikrobipesäkkeistä helposti mustan värin perusteella.

Homelive nyt käynnissä - reaaliajassa homeiden kasvua!
Oletko koskaan miettinyt, miten home todellisuudessa alkaa kasvamaan? Nyt sen voi nähdä omin silmin - turvallisesti ruudun takaa.
Homelive on Labroc Oy:n, rakentamisen elinkaaren laboratorion, järjestämä ainutlaatuinen livestriimi, jossa seuraamme homeiden kasvua 10 päivän ajan. Lähetys on nyt käynnissä ja jatkuu sunnuntaihin 23.11.2025 asti.

Homekasvun taustalla ovat usein rakenteisiin päässeet kosteusvauriot. Kun olosuhteet ovat otolliset – riittävästi kosteutta, sopiva lämpötila ja ravinteita – luonnossa ja sisäilmassa esiintyvät homeitiöt alkavat kasvamaan rakenne- ja materiaalipinnoilla.
Homelive tuo tämän prosessin näkyväksi ja näyttää sen, mitä harva on tullut ajatelleeksi: homeet ovat myös yllättävän kauniita.
Mitä näet Homelivessä?
- Homepesäkkeiden muodostumisen ja nukkamaisen peitteen ilmestymisen.
- Pesäkkeiden erilaisten värien ja kasvunopeuden kehityksen.
- Homeita, joita kosteusvaurioituneista rakennusmateriaaleista löydetään.
- Kuvioiden tai kirjaimien ilmestymisen kasvualustoille päivä päivältä.
Päätimme Labrocilla järjestää Homeliven, jolla voimme havainnollistaa homeiden kasvua rakenteissa suurelle yleisölle. Labroc toimii rakentamisen toimialalla puolueettomana laboratoriona tarjoten monipuolisia analyysipalveluja mm. sisäilmaongelmien selvityksiin.
Erilaiset homeet, joita Homelivessä tullaan näkemään, ovat samoja lajeja, joita tavataan kosteusvaurioituneissa rakenteissa. Liiallinen kosteus voi käynnistää prosessin, joka johtaa rakenteiden korjaustarpeisiin, kertoo Labrocin markkinointipäällikkö Tuuli Aho.
Tarkemmat home-esittelyt ja lähetyksen seuraaminen:
👉 https://labroc.fi/homelive/
Avainsanat
Yhteyshenkilöt
Tuuli AhomarkkinointipäällikköLabroc Oy
Vastaa Labroc Oy:n markkinoinnista ja viestinnästä.
Kuvat

Linkit
Labroc Oy - Rakentamisen elinkaaren laboratorio
Labroc Oy tuottaa laboratoriopalveluja kaikkiin rakentamisen eri vaiheisiin. Monipuolisen analyysi- ja palveluvalikoiman myötä tarjoamme asiantuntijoille tietoa tutkimusten ja selvitysten tueksi, ja autamme päämäärässä saavuttaa turvallinen ja terveellinen rakennettu ympäristö.
Analyysipalvelumme on jaettu neljään pääryhmään: Asbesti ja haitta-aineet, Sisäilma, Betoni ja Ympäristö. Olemme osa kansainvälistä GBA Groupia.
Labroc Oy on FINAS-akkreditointipalvelun akkreditoima testauslaboratorio T314, akkreditointivaatimus SFS-EN ISO/IEC 17025. Laboratorion pätevyysalue löytyy FINAS:n sivuilta.
Tilaa tiedotteet sähköpostiisi
Haluatko tietää asioista ensimmäisten joukossa? Kun tilaat tiedotteemme, saat ne sähköpostiisi välittömästi julkaisuhetkellä. Tilauksen voit halutessasi perua milloin tahansa.
Lue lisää julkaisijalta Labroc Oy
Homelive starttaa 14.11.2025 – lähde matkalle homeiden kasvun maailmaan10.11.2025 08:32:13 EET | Tiedote
Homelive on Labroc Oy:n, rakentamisen elinkaaren laboratorion, järjestämä 10 päivän livestriimi, jossa päästään seuraamaan homeiden kasvua reaaliajassa. Livestriimi on käynnissä 14.–23.11.2025, ja se tarjoaa ainutlaatuisen mahdollisuuden kurkistaa laboratoriomaailmaan – turvallisesti ruudun takaa.
Betoni- ja Ympäristölinjojen roolit laboratoriossa rakentamisen eri vaiheissa25.8.2025 11:59:26 EEST | Artikkeli
Kun tutkittavana materiaalina on betoni, valitseeko asiakas Betonilinjan vai Ympäristölinjan? Vastaus riippuu siitä, missä kohtaa rakentamisen elinkaarta ollaan menossa.
Uutishuoneessa voit lukea tiedotteitamme ja muuta julkaisemaamme materiaalia. Löydät sieltä niin yhteyshenkilöidemme tiedot kuin vapaasti julkaistavissa olevia kuvia ja videoita. Uutishuoneessa voit nähdä myös sosiaalisen median sisältöjä. Kaikki tiedotepalvelussa julkaistu materiaali on vapaasti median käytettävissä.
Tutustu uutishuoneeseemme